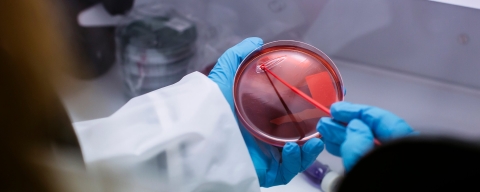
January 2020

Key information
For:
starting September 2026
UCAS code:
B940
Accreditation:
This course is Accredited
Typical offer:
112-120 from 3 A levels, or equivalent, to include 80 points in specific subjects
Showing content for section Overview
Overview
Biomedical scientists help identify rare diseases, diagnose disease, research disease processes and monitor patients’ treatment. On this accredited BSc (Hons) Biomedical Science degree, you’ll develop the expertise you need to start making your own contribution to the medical advances of the future.
This course is accredited by the Institute of Biomedical Science (IBMS) – a mandatory requirement if you want to work in the NHS after graduation. It's also accredited by the Royal Society of Biology.
Course highlights
- Put your knowledge to the test in our labs and simulation facilities, which are kitted out with industry-leading microscopes, spectroscopy and chromatography equipment
- Get involved with internationally recognised biomedical research into fields like neuro-oncology (the study of brain and spinal cord cancers) at our Institute of Life Sciences and Healthcare
- Take an optional work placement year at an Institute of Biomedical Science (IBMS) approved clinical training laboratory, and you'll be eligible to apply for registration as a Biomedical Scientist with the Health and Care Professions Council (HCPC) when you graduate
- Have a chance to take an international placement within a recognised biomedical research organisation as part of the Turing Scheme
5th
for biomedical science in the UK
(Guardian University Guide, 2026)
93%
of graduates in work or further study 15 months after this course
(latest HESA Graduate Outcomes Survey)
Top 30
for student satisfaction
(Times Higher Education, 2024)
92%
of students were positive about the support provided by teaching staff on this course
(NSS, 2025)
Accredited by:
This programme has been accredited by the Institute of Biomedical Science (IBMS) and the Royal Society of Biology, following an independent and rigorous assessment. Accredited degree programmes contain a solid academic foundation in biological knowledge and key skills, and prepare graduates to address the needs of employers. The accreditation criteria require evidence that graduates from accredited programmes meet defined sets of learning outcomes, including subject knowledge, technical ability and transferable skills.


Studying Biomedical Science at the University of Portsmouth
Students and staff at the School of Medicine, Pharmacy and Biomedical Sciences talk about our Biomedical Science BSc (Hons) course at the University of Portsmouth.
The University of Portsmouth, it's the best place to study.
It's a great degree. You can do pretty much anything with it.
And everyone's really friendly.
And that's when I knew, I’m on the right track.
Biomedical science is a really exciting career to go into and our degree is very much vocational. There are two main prongs to the biomedical science pathway. One of those is kind of research orientated and there's another part which is diagnostic.
My favourite part is working in the lab.
One thing that I love most about this subject is the practical aspect.
The amount of practice and the skills you get.
It gives you an opportunity to really learn faster and aid us in comprehending better.
Lecturers, professors, everyone's eager to help.
A number of the staff here are health and care profession registered biomedical scientists and they have their own disciplinary specialties and they all bring their own unique perspective to the subject. Biomedical science, here at Portsmouth, follows the IBMS curriculum so it's an IBMS accredited course.
And also the Royal Society of Biology. Biomedical science is a long established course.
So we're very innovative with the way we teach and assess so we get students to write, you know, social media posts. We get the students to create apps that are involved in clinical guidelines. I think that we've introduced an escape room assessment that we use. We use a lot of case based approaches so we take patient case studies throughout the whole of the course and we break them down and build them back up again.
We look at people and what they’re struggling with, what disease they have, what symptoms they have.
So I think that variety, that kind of contemporary feel to biomedical science that we bring, it's really one of the main reasons why people come to study at Portsmouth. We also have have a really important clinical placement option.
Within that year you do your registration portfolio. You see the difference when students come back. You know, they’ve got that much more experience.
And as a consequence, when they graduate, they can register with the HCPC as biomedical scientists and enter that profession immediately after they graduate.
When you get a degree in biomedical science, you're not restricted in anything. It's just amazing. I love it’s location, it’s in a lovely city.
There’s coastal sites, beautiful sea view.
It’s really close to London. You can always hop on the train. It's just 90 minutes.
Portsmouth is a really ambitious university.
You really learn to think critically like a clinician.
We’re invested in size, we’re invested in knowledge creation, we’re invested in career opportunities. It's an exciting time to be learning about biomedical science. We provide a brilliant opportunity for our students to really flourish in a global environment.
Contact information
Contact AdmissionsClearing is open
This course is available through Clearing.
Clearing 2025 is now closed
Clearing FAQs
To work out your UCAS points, use our UCAS Calculator to work out how many UCAS points you have.
The tariff calculator will allow you to see what grades you need to get into your preferred course at Portsmouth.
Even if you don't receive the grades you need, we recommend still calling us on 023 9284 8090 as we still may be able to consider you for a course
You can apply through Clearing if:
- You don't meet the conditions of your offer for your firm (first) or insurance (second) choice courses
- Your exam results are better than you expected and you want to change your course or university
- You don't hold any offers
- You've accepted an offer but changed your mind about the course you want to do
- You're applying for the first time after 30 June 2025
After we make you an offer we'll send you a confirmation email. This email will let you know what you need to do next and it will tell you what you need to provide us. In some instances we may ask you to send us copies of certificates or other information.
If you've previously applied through UCAS you'll need to use your UCAS Hub to accept our offer by adding us as your Clearing choice.
If you're having issues, please contact us on +44 (0)23 9284 8090 or admissions@port.ac.uk
Once you've accepted your Clearing course offer, we'll be in touch with details of available accommodation in the area. This will include our latest hall availability and support to find local rented accommodation via portsmouthstudentpad.co.uk
See our accommodation page for more information.
No, it's not too late and you should make your application for student finance as soon as possible. You don't have to wait for your results. You can make your application now and just amend it when you know where you're going to be.
If you've already applied for your student loan, you'll need to log into your account and update details about your new course/university. If you haven't applied for your student loan yet, don't panic. Apply today – it only takes 30 minutes.
Find out more in our Student finance for Clearing guide.
If you're an EU or international student and you need a visa to study here, you need to start the process quickly as visas can take some time to come through. Get in touch with our visa support team if you have a question or problem.
See more on visa advice.
If you would like further information or guidance, please contact our international office.
Entry requirements
BSc (Hons) Biomedical Science entry requirements
Typical offers
- A levels - BBB-BBC
- UCAS points - 112-120 from 3 A levels, or equivalent, to include 40 points from Biology and 40 points from a second Science subject or Mathematics. For A levels which include a separate science practical component, a pass is desirable and may strengthen an application. (calculate your UCAS points)
- T-levels - Merit. Acceptable T Level Subjects:
T Level in Health, T Level in Healthcare Science, T Level in Science (Acceptable Occupational Specialisms: Laboratory sciences) - BTECs (Extended Diplomas) - DDM-DMM
Must be in a Science or Applied Science subject - International Baccalaureate - 27
You may need to have studied specific subjects – find full entry requirements and other qualifications we accept.
English language requirements
- English language proficiency at a minimum of IELTS band 6.0 with no component score below 5.5.
See alternative English language qualifications.
We also accept other standard English tests and qualifications, as long as they meet the minimum requirements of your course.
If you don't meet the English language requirements yet, you can achieve the level you need by successfully completing a pre-sessional English programme before you start your course.
We look at more than just your grades
While we consider your grades when making an offer, we also carefully look at your circumstances and other factors to assess your potential. These include whether you live and work in the region and your personal and family circumstances which we assess using established data.
If you don't meet the entry requirements, you may be able to join this course after you successfully complete a foundation year.
Your facilities
Pharmacy and Biomedical Science Teaching Centre
Practise the skills needed to diagnose and help people manage diseases, including collaborative microscopy - examining 3D microscopic images on a big screen with academics and other students.

Pharmaceutics Laboratories
Develop a better understanding of the causes and consequences of diseases in these labs, as well as the skills and expertise needed to develop and test new drugs.

Institute of Life Sciences and Healthcare
Our multidisciplinary research environment supports the translation of science for societal benefit.

Biophysical laboratories
Use professional-standard equipment to explore how the structures and functions of molecules change under different conditions.

Careers and opportunities
Whether it's processing tests for diseases such as coronavirus or providing diagnosis services to GPs, accident and emergency departments and other health services, registered Biomedical Scientists play a key role in public health.
They analyse fluid and tissue samples from patients in order to identify diseases or evaluate the effectiveness of different treatments. In fact, more than 70% of NHS diagnoses are based on lab findings by biomedical scientists, so it's a profession that's always in high demand.
On this BSc (Hons) Biomedical Science degree, you’ll learn to diagnose, monitor and manage health conditions. You’ll learn from our outstanding team of biomedical scientists and researchers whose work is shaping the understanding of conditions, such as brain tumours.
HCPC registration
After you've graduated and completed 12 months of work-based learning within an Institute of Biomedical Science (IBMS) approved clinical training laboratory, you'll be eligible to apply for registration with the Health and Care Professions Council (HCPC) and work as a Biomedical Scientist in the NHS and private settings.
Royal Society of Biology membership
You can also apply for Associate Membership of the Royal Society of Biology, which gives you access to professional networks and exclusive grants and awards.
The lecturers support you and encourage you to get involved with the endless opportunities available, so you can make the most of your student experience, while also gaining key transferable skills.
What areas can you work in with a biomedical science degree?
You can use your biomedical science knowledge in related fields such as:
- scientific research
- teaching (with further training)
- scientific writing
- medical sales
- medicine and dentistry (with further training at medical or dental school)
- becoming a Physician Associate (with further training)
- postgraduate study or research
Graduate roles and destinations
Roles recent graduates have gone on to do include:
- biomedical scientist
- clinical trial coordinator
- medical lab assistant
- science teacher
- dental nurse
- medical affairs executive
They've gone on to work for companies such as:
- Pall Europe
- Pfizer
- Roche
- Viapath
- Imperial College London
- Bristol Royal Infirmary

Read about Simon's post-grad career in the NHS"Choosing to study biomedical science at Portsmouth meant I was able to enter my current career directly from university."
Potential salary
As a biomedical scientist in the NHS in 2021, you could expect a starting salary of £25,655 moving up to £31,534 (Band 5).
With more experience, you could earn from £32,306 to £39,027 (Band 6) and with a role as a senior biomedical scientist, you could make between £40,057 (Band 7) and £53,219 (Band 8a), or more as a consultant biomedical scientist.
Placement year
After your second or third year, you can do an optional work placement year to get valuable longer-term work experience in the industry. Placements give you the opportunity to apply what you've learnt so far in a real workplace, boosting your employability and making you attractive to employers after graduation.
If you do your placement in an IBMS-approved NHS pathology laboratory, you can complete the IBMS registration portfolio. This means you'll be eligible to apply for registration with the HCPC as a Biomedical Scientist when you graduate.
Our students have completed clinical placements at the following hospitals:
- University Hospital Southampton
- Queen Alexandra Hospital, Portsmouth
- Royal Bournemouth Hospital
- Poole Hospital
- Salisbury District Hospital
Whichever route you choose, you'll receive support and guidance. Our specialist team of Science and Health Careers advisors can help you with finding a work placement and improving your employability skills. They'll provide you with a database of placement vacancies, support with your job search – including help with applications and interviews – and support throughout your placement year.
Summer research placement
You'll also have the opportunity to apply to a study exchange scheme, which involves a summer research placement through the Turing Scheme.
Ongoing careers support
After you graduate, you can get help, advice and support for up to 5 years from our Careers and Employability Service as you advance in your career.
Modules
Each module on this course is worth a certain number of credits.
In each year, you need to study modules worth a total of 120 credits. For example, four modules worth 30 credits each or two modules worth 45 credits each and one module worth 30 credits.
What you'll study
Core modules
All modules in this year are core.
This module is your launchpad into biomedical science, designed to build your confidence while introducing the science that underpins modern healthcare. from day one, you'll develop the study skills you need to succeed at university, learning how to work independently, manage your time and think critically about science.
You'll explore how the human body works from the inside out, starting with cells and biological molecules before moving on to tissues, organs and body systems. along the way, you'll be introduced to microbiology, genetics and inheritance, helping you understand how health is maintained and how disease can develop when normal processes break down.
You'll also get your first taste of the laboratory disciplines that biomedical scientists work in every day, including haematology, immunology, biochemistry, histopathology and transfusion science. these topics are brought to life through real-world examples that show how laboratory results inform diagnosis, treatment and patient care. neuroscience and pharmacology add another layer, linking nerve signalling and drug action to clinical practice and medicines safety.
Practical work is a key part of the module, giving you hands-on experience of laboratory techniques, safe working, data handling and scientific maths. through case studies, group projects and supportive tutorials, you'll start to think like a biomedical scientist and prepare for the next stage of your degree.
Core modules
You'll explore conditions such as respiratory infections, impaired gas exchange, anaemia, thrombosis, vascular disease and immune dysfunction, linking symptoms to underlying cellular and biochemical changes.
Immunological concepts are also expanded to provide a solid grounding in transfusion science.
Laboratory sessions, data interpretation and case-based discussions highlight the role of biomedical scientists in investigating disease and understanding how the body responds, and sometimes fails to adapt, in extreme environments.
You'll develop confidence in a range of laboratory techniques, safe working and data analysis, while learning how research projects are planned, funded and managed, from forming hypotheses to understanding ethics and consent.
You'll also explore evidence-based medicine, clinical trials and regulation, helping you judge the quality of scientific evidence and reflect on future careers in biomedical research.
You'll learn how to analyse and interpret different types of biomedical data, from laboratory experiments to clinical and healthcare datasets, using modern digital tools.
By the end of the module, you'll understand how data-driven approaches support discovery, innovation and decision-making in biomedical research and real-world healthcare.
Optional modules
You'll explore how the nhs is structured, alongside essential topics such as accreditation, audits, equality and diversity, safeguarding, licensing, health and safety and good laboratory practice.
By linking these areas to the ibms registration portfolio, the module helps you understand what is expected of you in practice and builds confidence for working safely and professionally with patients and colleagues.
You'll learn how organs develop, how things can go wrong before birth, and how cells and stem cells help repair tissues later in life, linking development to disease and modern medicine.
Taught by active researchers, the module combines lectures, workshops and practical sessions to build your understanding, curiosity and confidence in this fascinating area of biomedical science.
The module will: develop graduate skills inclusive of enterprise, self-starting, effective communication, effective team work to include cooperation, negotiation and diversity, effective project management, problem solving, decision making, independent development by reflection and handling critical feedback, research and critical skills analysis, effective use of it, numeracy and literacy.
It also provides a medium for students to develop 'simulated business relationships' to enhance confidence and become assertive professionals. outside practitioners will also contribute to the learning to ensure transference to the real world of business.
Core modules
You'll explore conditions such as renal failure, nervous system disorders, inflammatory bowel disease, liver disease and haematological cancers, learning how laboratory tests are used to diagnose, classify and monitor disease.
Case-based learning and an interprofessional clinical event bring everything together, helping you apply your knowledge, communicate clearly and think like a biomedical scientist in practice.
You'll explore inherited and acquired disorders, including mitochondrial disease, sepsis and infectious pathology, linking genetic change to cellular abnormalities and clinical outcomes.
Through examples such as stem cell transplantation, solid organ transplant and transfusion practice, you'll see how molecular pathology underpins diagnosis, treatment and modern biomedical care.
Optional modules
Working in small teams, you'll follow problem-based learning pathways that mirror clinical practice, using evidence to evaluate diagnostic decisions and laboratory data.
Through peer review and guided collaboration, you'll build confidence in critical thinking, teamwork and professional communication, developing the skills needed to approach diagnostic pathology like a biomedical scientist.
You'll engage directly with researchers driving biomedical science forward through face-to-face sessions, seminars and guided discussion, gaining insight into how discoveries move from the lab towards patient care.
Alongside this, you'll build confidence in literature searching, data analysis, scientific writing and critical thinking, helping you shape your future research ambitions and refine your career goals.
You'll develop practical, problem-solving and transferable skills that employers value, while building confidence in professional practice.
Through reflection and supported planning, the module helps you understand your progress, strengthen your employability and prepare for lifelong learning as a graduate.
In this research-led module you'll explore current hot topics in developmental biology. embryonic development not only is a fundamental life process but also holds the key to understanding birth defects and regeneration.
Through seminars and workshops you'll delve into current research papers, giving you the opportunity to learn about advanced methods and to analyse and interpret experimental evidence.
With the focus on up-to-date research, you'll also develop critical and reflective knowledge and understanding of developmental biology and its medical applications.
Working closely with an academic supervisor, you'll design, carry out and analyse a laboratory, computational or data-driven project, gaining experience in ethics, safety, problem-solving and scientific communication.
Alongside your research, tailored tutorials support career planning, applications and interview skills, helping you feel confident and prepared for life beyond university.
Fast-track your personal and professional development with the opportunity study abroad in a higher education setting through a one year study placement or gain work experience in an NHS or industrial placement.
Depending what you choose, you'll develop intercultural awareness and other skills relevant to your future employability by undertaking additional learning in an international environment, or have the opportunity to or take on an optional year-long placement module where you'll work in a biomedical role and reflect on what you've done, the skills and abilities you've gained, and challenges you have met and overcome.
This is a Connected Degree
We're the only university that gives you the flexibility to choose when to take a work placement. Take it after your 2nd year, before returning to finish your studies. Or after your final year, connecting you into the workplace.
If you're not sure if or when to take your placement, don't worry. You'll have plenty of time to settle into your studies and explore your options before making your choice.
Changes to course content
We use the best and most current research and professional practice alongside feedback from our students to make sure course content is relevant to your future career or further studies.
Therefore, some course content may change over time to reflect changes in the discipline or industry. If a module doesn't run, we'll let you know as soon as possible and help you choose an alternative module.
How you're assessed
- essays
- laboratory reports
- workshops
- presentations
- group work
- practical assessment classes
You’ll be able to test your skills and knowledge informally before you do assessments that count towards your final mark.
You can get feedback on all practice and formal assessments so you can improve in the future.
Teaching
Teaching methods on this course include:
- lectures
- seminars
- practical lab work
- guided reading
- collaborative and peer-assisted learning
- simulation
Academic staff have expertise in clinical practice and research. Our HCPC registered Biomedical Scientists work closely with the Institute of Biomedical Science (IBMS) advisory panels to ensure what you learn reflects new development and technology in the field.
You can access all teaching resources on Moodle, our virtual learning environment, from anywhere with a Web connection.
For more about the teaching activities for specific modules, see the module list above.
How you'll spend your time
One of the main differences between school or college and university is how much control you have over your learning.
We use a blended learning approach to teaching, which means you’ll take part in both face-to-face and online activities during your studies. As well as attending your timetabled classes you'll study independently in your free time, supported by staff and our virtual learning environment, Moodle.
A typical week
We recommend you spend at least 35 hours a week studying for your degree. In your first year, you’ll be in timetabled teaching activities such as tutorials, lectures, seminars and practical classes and workshops for about 14 hours a week. The rest of the time you’ll do independent study such as research, reading, coursework and project work, alone or in a group with others from your course. You'll probably do more independent study and have less scheduled teaching in years 2 and 3, but this depends on which modules you choose.
Most timetabled teaching takes place during the day, Monday to Friday. You may occasionally need to go to University and course events in the evenings and at weekends.
Term dates
The academic year runs from September to June. There are breaks at Christmas and Easter.
Supporting you
The amount of timetabled teaching you'll get on your degree might be less than what you're used to at school or college, but you'll also get support via video, phone and face-to-face from teaching and support staff to enhance your learning experience and help you succeed. You can build your personalised network of support from the following people and services:
Types of support
Your personal tutor helps you make the transition to independent study and gives you academic and personal support throughout your time at university.
As well as regular scheduled meetings with your personal tutor, they're also available at set times during the week if you want to chat with them about anything that can't wait until your next meeting.
You'll have help from a team of faculty learning support tutors. They can help you improve and develop your academic skills and support you in any area of your study.
They can help with:
- improving your academic writing (for example, essays, reports, dissertations)
- understanding and using assignment feedback
- managing your time and workload
- revision and exam techniques
During term time, Faculty Academic Skills Tutors (AST) are available for bookable 1-to-1 sessions, small group sessions and online sessions. These sessions are tailored to your needs.
Support is available for skills including:
- University study
- Getting into the right study mindset
- Note-taking and note-making skills
- Referencing
- Presentation skills
- Time management, planning, and goal setting
- Critical thinking
- Avoiding plagiarism
If you have a disability or need extra support, our Disability Advice team will give you help, support and advice.
You can get personal, emotional and mental health support from Student Wellbeing, in person and online. This includes 1–2–1 support as well as courses and workshops that help you better manage stress, anxiety or depression.
If you require extra support because of a disability or additional learning need our specialist team can help you.
They'll help you to
- discuss and agree on reasonable adjustments
- liaise with other University services and facilities, such as the library
- access specialist study skills and strategies tutors, and assistive technology tutors, on a 1-to-1 basis or in groups
- liaise with external services
Library staff are available in person or by email, phone, or online chat to help you make the most of the University’s library resources. You can also request one-to-one appointments and get support from a librarian who specialises in your subject area.
The library is open 24 hours a day, every day, in term time.
If English isn't your first language, you can do one of our English language courses to improve your written and spoken English language skills before starting your degree. Once you're here, you can take part in our free In-Sessional English (ISE) programme to improve your English further.
Course costs and funding
Tuition fees
- UK/Channel Islands and Isle of Man students – £9,790 per year (may be subject to annual increase)
- EU students – £10,300 (including EU Scholarship – may be subject to annual increase)
- International (non-EU) students – £19,950 per year (subject to annual increase)
Funding your studies
Find out how to fund your studies, including the scholarships and bursaries you could get. You can also find more about tuition fees and living costs, including what your tuition fees cover.
Applying from outside the UK? Find out about funding options for international students.
Additional course costs
These course-related costs aren’t included in the tuition fees. So you’ll need to budget for them when you plan your spending.
Additional costs
Our accommodation section shows your accommodation options and highlights how much it costs to live in Portsmouth.
You’ll study up to 6 modules a year. You may have to read several recommended books or textbooks for each module.
You can borrow most of these from the Library. If you buy these, they may cost up to £60 each.
We recommend that you budget £75 a year for photocopying, memory sticks, DVDs and CDs, printing charges, binding and specialist printing.
If your final year includes a major project, there could be cost for transport or accommodation related to your research activities. The amount will depend on the project you choose.
You’ll get free safety equipment at the start of the course. However, you may have to pay a small amount to replace lost or damaged equipment.
If you take optional work-based learning units, you’ll need to pay for travel to and from placements, which normally costs around £50.
If you take a placement year or study abroad year, tuition fees for that year are as follows:
- UK/Channel Islands and Isle of Man students – £1,468 a year (may be subject to annual increase)
- EU students – £1,545 a year (including EU Scholarship - may be subject to annual increase)
- International students – £3,000 a year (subject to annual increase)
Apply
Ready to apply?
To start this course in 2026, apply through UCAS. You'll need:
- the UCAS course code – B940
- our institution code – P80
If you'd prefer to apply directly, use our online application form.
You can also sign up to an Open Day to:
- Tour our campus, facilities and halls of residence
- Speak with lecturers and chat with our students
- Get information about where to live, how to fund your studies and which clubs and societies to join
If you're new to the application process, read our guide on applying for an undergraduate course.
Applying from outside the UK
As an international student you'll apply using the same process as UK students, but you’ll need to consider a few extra things.
You can get an agent to help with your application. Check your country page for details of agents in your region.
Find out what additional information you need in our international students section.
If you don't meet the English language requirements for this course yet, you can achieve the level you need by successfully completing a pre-sessional English programme before you start your course.
Admissions terms and conditions
When you accept an offer to study at the University of Portsmouth, you also agree to abide by our Student Contract (which includes the University's relevant policies, rules and regulations). You should read and consider these before you apply.

